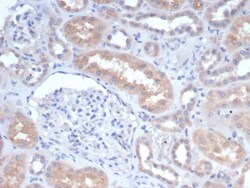
GCLM Antibody (GCLM/4068), Novus Biologicals 100 &mu;g, Unconjugated:Antibodies,

missing translation for 'onlineSavingsMsg'
Learn More
Learn More
GCLM Antibody (GCLM/4068), Novus Biologicals™
Mouse Monoclonal Antibody
Brand: Novus Biologicals NBP3-23884-100ug
This item is not returnable.
View return policy
Description
GCLM Monoclonal antibody specifically detects GCLM in Human samples. It is validated for Immunohistochemistry (Paraffin)
Specifications
| GCLM | |
| Monoclonal | |
| 0.2 mg/mL | |
| Immunohistochemistry-Paraffin : 1-2 μg/mL | |
| Gamma-ECS regulatory subunit, Gamma-glutamylcysteine synthetase regulatory subunit, GCS light chain, GLCLRglutamate--cysteine ligase regulatory subunit, glutamate-cysteine ligase (gamma-glutamylcysteine synthetase), regulatory(30.8kD), Glutamate--cysteine ligase modifier subunit, glutamate-cysteine ligase regulatory protein, glutamate-cysteine ligase, modifier subunit, GSC light chain | |
| Recombinant full-length human GCLM protein | |
| 100 μg | |
| Cancer | |
| 2730 | |
| Store at 4°C. | |
| IgG2a κ |
| Immunohistochemistry (Paraffin) | |
| GCLM/4068 | |
| Unconjugated | |
| 10 mM PBS with 0.05% BSA | |
| Mouse | |
| Protein A or G purified | |
| RUO | |
| Primary | |
| Human | |
| Purified |
Product Content Correction
Your input is important to us. Please complete this form to provide feedback related to the content on this product.
Product Title
Spot an opportunity for improvement?Share a Content Correction